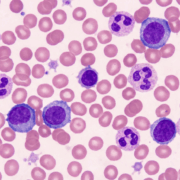
blood cells

AI achieves superhuman accuracy in blood cell classification using generative diffusion models
Researchers have developed CytoDiffusion, a diffusion-based generative classifier that surpasses clinical experts in blood cell image analysis. The system demonstrates remarkable capabilities in anomaly detection, uncertainty quantification and domain adaptation whilst generating synthetic images indistinguishable from real samples.